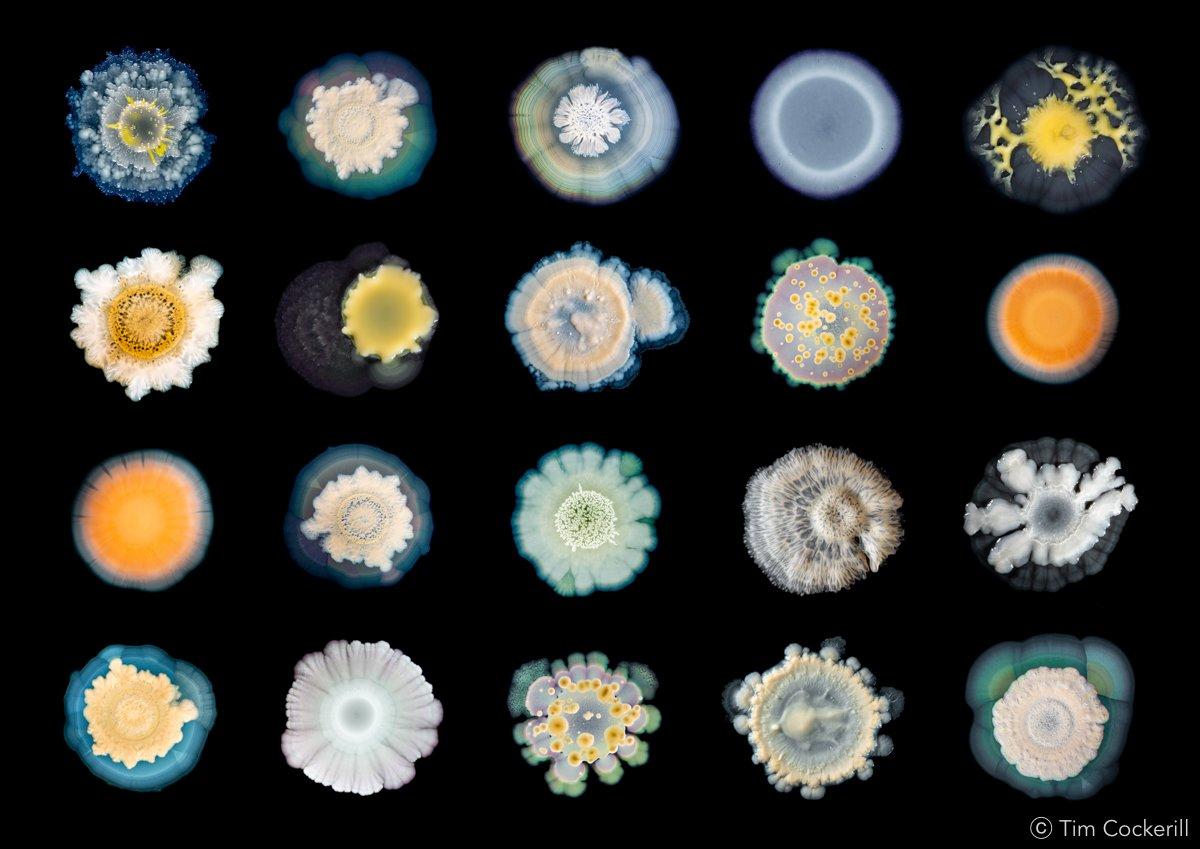

The exhibitions you must see in 2025

Discover a golden age of painting in 14th-century Italy, the iconic textiles designed by Swedish superstore IKEA, Marie Antoinette’s enduring influence on fashion, and so much more in a new year of must-see exhibitions. Here's our guide to the ones you won't want to miss in 2025.
Looking to experience the best art and culture in 2025? Explore our round-up of the biggest exhibitions across the UK to see throughout the new year.
Bookmark this page and mark your shiny new calendars, because you won’t want to miss these.
And don’t forget to pack a National Art Pass to make great savings at lots of these venues year-round.
Winter
Want to start your new year with a bang? The first few months of 2025 are jam-packed with exhibitions to get you out of the house and into some culture.
Every year, Somerset House in London deep-dives into a topic in a blockbuster exhibition, and this year they’re digging into soil to uncover its power and the vital role it plays in the future of the planet.
Pop art fanatics, this one’s for you – the Holburne Museum in Bath are examining photography’s pivotal role in portraiture since the 1960s. Experience iconic works by artists including Peter Blake, Pauline Boty, Richard Hamilton and Andy Warhol. And while you’re there, check out the museum’s simultaneous Diedrick Brackens exhibition, an artist who blends textile-making techniques from West Africa and the American South to explore history and identity.
If Paul Mescal stepping into Russell Crowe’s Gladiator sandals has inspired you to learn more about Roman history, don’t miss Dorset Museum and Art Gallery’s Gladiators of Britain exhibition which reveals the legacy and spectacle of the Roman fighters in Britain.
Looking for more family-friendly exhibitions that are educational and entertaining at the same time? Young V&A’s Making Egypt will take you on an immersive story told by gods, exploring ancient Egypt’s influence on art, design and culture.
Robot animals form a zoo at the Horniman Museum, where animals are recreated with machines and gadgets to demonstrate the amazing things they do to survive, from colour-changing chameleons to night sight in bats. This immersive exhibition will be sure to keep kids entertained.

Fashion, music and youth culture are captured in two blockbuster exhibitions in London. The Face Magazine: Culture Shift at the National Portrait Gallery spotlights the cult publication that documented British culture from the 80s to the early 2000s. Meanwhile Tate Modern spotlights the boundary-pushing artist Leigh Bowery, who revolutionised art, fashion and performance.
And at the Hayward Gallery, experience pioneering works by a feminist artist from Manchester’s punk scene. Linder blends photography, performance and sculpture to dissect the body and its representations, examining our changing attitudes to lifestyles, sex, food and fashion. At the same venue, Mickalene Thomas stages large-scale portraits of Black women radically luxuriating.
Post-war Germany’s history and identity are explored in Anselm Kiefer’s rarely seen early works, on display at the Ashmolean Museum in Oxford. And if you’re unable to catch this one, the Royal Academy are presenting Kiefer alongside Van Gogh in a major exhibition opening later in June.

Discover the vibrant paintings of the Scottish Colourists at Dovecot Studios in Edinburgh, shown alongside their European contemporaries, including Matisse and key figures from the Bloomsbury Group.
In Manchester, the Whitworth celebrates 250 years since JMW Turner's birth by showcasing a major collection of prints that haven't been displayed in over 100 years. And later in the season, catch Women in Revolt!, the feminist art blockbuster exhibition that has previously toured to Tate Britain and National Galleries of Scotland.

Surrealist painter, experimental writer and practising occultist Ithell Colquhoun is under the spotlight at Tate St Ives in a landmark exhibition displaying over 200 works of art, which chart her fascination with the interconnections between art, sexual identity, ecology and occultism. The exhibition will tour to Tate Britain in June.
Hungry for another big painting show? The Barbican spotlights the creative force of Noah Davis, whose figurative paintings celebrate the beauty in everyday life.

Spring
Step into spring and Siena’s golden age at the National Gallery in London to experience a major turning point in art history. Meet the 14th-century painters who paved the way for a painting style that had never been seen before.
In keeping with the promise of a new season, gardens become the focus of two major exhibitions. Gardening at the British Library unearths the transformative power of gardening, while Garden Futures: Designing with Nature at V&A Dundee digs into the history of garden design and the importance of outdoor spaces.

Lovers of sculpture are in for a treat. At Jupiter Artland near Edinburgh, contemporary artist Jonathan Baldock presents a new body of work that combines dark humour with folklore and personal biography to explore our relationship with our bodies.
The first major retrospective of British artist Helen Chadwick in 25 years opens at the Hepworth Wakefield. While you’re there, catch contemporary painter Caroline Walker’s exhibition about motherhood, which will be touring to Pallant House Gallery in Chichester in November.
And the Barbican presents an exhibition series spotlighting the influence of Swiss sculptor Alberto Giacometti on contemporary sculpture, opening with an exhibition by Huma Bhabha in May, followed by Mona Hatoum in September and Lynda Benglis in February 2026.

King James’s reign as the first monarch of Scotland, England and Ireland is examined through a contemporary lens at the Portrait in Edinburgh. Marvel at ornate paintings, sparkling jewels, and important works of art from the 16th and 17th centuries in this immersive exhibition, exploring themes of national identity, queer history, belief and spirituality.
The story of modernism is re-examined at Towner Eastbourne to include artists connected to Sussex who have often been excluded from the established narrative around modern art and culture. Spanning a wide range of creative forms, from art and sculpture to music and film, the exhibition asks what it means to look at art through a regional lens and how places outside of metropolitan centres are perceived.
If staying in the know with the coolest contemporary art is your thing, don’t miss Ed Atkins’s first major UK exhibition, at Tate Britain. Immerse yourself in large-scale installations that combine film, painting, writing, drawing and embroidery to dissect the impact of technology on images and our understanding of ourselves.

Summer
The summer season ushers in a new wave of exhibitions to keep you entertained.
The radical contributions of disabled, Deaf, and neurodiverse artists and designers from the 1940s to today are celebrated at V&A South Kensington. And later in the year, the Henry Moore Institute in Leeds presents the groundbreaking exhibition Beyond the Visual: Blindness and Expanded Sculpture, exploring how to engage with contemporary sculpture using senses other that sight.
From their Billy bookcase to their legendary meatballs, there is so much to love about the popular home décor and furniture retailer IKEA. In the summer, Dovecot Studios shines a light on the Swedish company’s iconic textiles that have decorated people’s homes over the last 60 years.
And immerse yourself in a monumental exhibition by Andy Goldsworthy at the Royal Scottish Academy. Over 200 works, including photographs, sculptures and site-specific installations using natural materials, will go on display.

Autumn
Fashion fans are in for a treat in the autumn months with blockbusters across London, from the regal Marie Antoinette Style at V&A South Kensington to the stylish Cecil Beaton’s Fashionable World at the National Portrait Gallery. Plus, the war and fashion photographer and surrealist Lee Miller takes centre stage with a major exhibition at Tate Britain.
Can we stop killing each other? Norwich's Sainsbury Centre asks more hard-hitting questions in the autumn edition of their bold exhibition programme, getting a deeper insight into the darker side of humanity and how it is explored in culture.

Compton Verney will stage a solo exhibition by Hong Kong-born artist Renee So, who explores Chinese history and identity with darkly playful objects that signify important and sometimes brutal moments.
At the Design Museum, step into the 1980s nightclub where fashion, music and design collided. Blitz welcomed superstars including David Bowie and Boy George, and has been credited as a hotspot for the New Romantics. In November, pop back to see the museum's celebration of eccentric filmmaker Wes Anderson.
And last (but not least) – Charleston in Firle highlights writer and critic Roger Fry's lesser known career as a painter, while Charleston in Lewes stages an exhibition exploring the life and work of romantic and creative partners Robert MacBryde and Robert Colquhoun.
